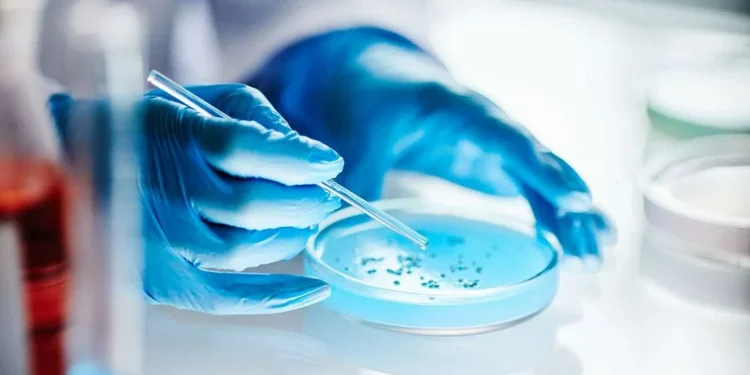

O Chile planeja enviar experimentos tecnológicos e biológicos à Estação Espacial Internacional (EEI), informou a Crónica Digital, parceira da TV BRICS. A iniciativa envolve diversas universidades do país e busca expandir o conhecimento sobre vida e tecnologias fora da Terra.
Como parte do projeto, os pesquisadores enviarão à EEI um contêiner especialmente desenvolvido para operar em condições extremas, como a microgravidade e a radiação espacial. Esse pequeno laboratório permitirá testar tanto organismos biológicos quanto equipamentos tecnológicos, promovendo avanços científicos em múltiplas áreas da exploração espacial.
Entre os experimentos previstos estão análises de organismos biológicos e o estudo do comportamento de sequências de DNA sintético em microgravidade. A missão também inclui a avaliação de dispositivos submetidos às condições adversas do espaço, a fim de verificar sua resistência e funcionalidade.
Segundo os pesquisadores, a missão representa uma oportunidade única para compreender como conduzir pesquisas em ambiente espacial. Além disso, eles ressaltam que a iniciativa evidencia o potencial humano e tecnológico do Chile, reforçando seu papel no setor espacial internacional.
Durante a permanência do contêiner na EEI, os dados serão transmitidos periodicamente à Terra por meio de imagens e vídeos, permitindo o monitoramento contínuo dos experimentos. Ao término da missão, o material coletado será submetido a análises mais aprofundadas em laboratório
Fonte: tvbrics